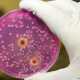

Нетрадиционная медицина

Предательское першение горла, заложенность носа, слабость и озноб. Всем известны эти симптомы гриппа, которые выбивают нас из ритма нормальной полноценной жизни. Ежегодно человечество тратит миллиарды долларов на борьбу с этим опасным недугом. Но большинство из …

Фарингит – острое воспалительное заболевание слизистой глотки, которое сопровождается сильной болью в горле. Причиной фарингита может стать грибковая, бактериальная или вирусная инфекция. Иногда болезнь может развиться вследствие каких-либо раздражителей (загрязнения воздуха или воздействия химических веществ).
Если …

Каждому знакома ситуация, когда просыпаешься посреди ночи и не можешь снова заснуть из-за храпа партнера или члена семьи. Значительная часть человечества храпит, причем некоторые люди храпят довольно громко, и это становится предметом для шуток.
Большинство людей …
Молочница или кандидоз — воспаление слизистой оболочки влагалища, которое вызвано грибковой инфекцией. Заболевание сопровождается густыми белыми выделениями, а в запущенном состоянии неприятным зудом и болями.
Причинами кандидоза чаще всего являются сниженный иммунитет, прием антибиотиков, стресс, беременность, …

Тошнота – знакомое каждому ощущение, которое трудно выразить словами. Она может быть вызвана множеством причин: пищевым отравлением, обезвоживанием, непереносимостью транспорта, беременностью, побочным действием некоторых лекарственных препаратов.
Следует знать, что частые приступы тошноты являются результатом серьезных изменений, …

Геморрой или воспаленные венозные узлы, образованные в прямой кишке, приносят страдания более половине человечества. Причин этого заболевания – множество. В первую очередь, к ним относят запоры, сидячий образ жизни, воспалительные заболевания, роды, чрезмерные физические нагрузки.
В …

Чрезмерное переохлаждение, гиповитаминоз, сухой загазованный воздух в сочетании с ослабленным иммунитетом – вот далеко не полный перечень возможных причин ангины – воспалительного заболевания глотки и миндалин. Главное условие лечения ангины – удаление гнойного налета с …

Пяточная шпора может вызывать довольно неприятные болевые ощущения во время ходьбы, которые вызваны давлением костных выростов на мягкие ткани стопы. Одной из основных причин появления этих кальциевых образований является плантарный фасцит — воспаления соединительной структуры …

Гемоглобин — железосодержащий белок, присутствующий в красных кровяных клетках, который отвечает за транспорт кислорода по всему организму. Гемоглобин также помогает клеткам избавляться от углекислого газа, доставляя его в легкие.
Уровень гемоглобина важен для полноценной жизнедеятельности и …

Насморк или ринит – самое распространенное заболевание осенне-зимнего периода. Носовая полость согревает, фильтрует и увлажняет вдыхаемый воздух, являясь защитным барьером нашего организма.
При неправильном и несвоевременном лечении насморк переходит в затяжную форму и может привести к …

Повышенный уровень сахара в крови – довольно распространенное явление, особенно часто наблюдающееся у людей, которые перешагнули полувековой рубеж. Стоит отметить, что не всегда увеличенный уровень глюкозы в крови является признаком развития сахарного диабета. Отклонения этого …

В современный век стрессов, перенасыщения информацией, гиподинамии и переутомления бессонница стала весьма распространенным явлением. По статистике, проблемы со сном имеются у 40% людей. Бессонница может проявляться в разных формах: одни просыпаются среди ночи и больше …

Повышение внутриглазного давления нарушает работу оптической системы глаза и, в конечном итоге, может привести к нарушениям зрения. Механизмы обменных процессов в глазном яблоке во многом зависят от стабильности показателя внутриглазного давления, которые в норме, в …

Одной из причин сердечных заболеваний является высокий уровень «плохого» холестерина или, как его называют, LDL-холестерин. Единственный способ снизить его содержание в крови — нормализовать свой ежедневный рацион. Продуктов, позволяющих несколько уменьшить уровень вредного холестерина, множество.
Все …

Грибковое поражение ногтевых пластинок или онихомикоз вызывается дрожжевыми или плесневыми грибами и может появиться как на ногах, так и на руках. Риск появления онихомикоза возрастает у людей преклонного возраста. Внешне это заболевание проявляется различными изменениями …

Артрит – воспалительное заболевание суставов, которое может привести к ограничению двигательной активности, а в тяжелых случаях даже инвалидности. Согласно статистике, артритом болеет каждый сотый человек. Распространенность заболевания характерна для всех возрастных категорий, но чаще всего …